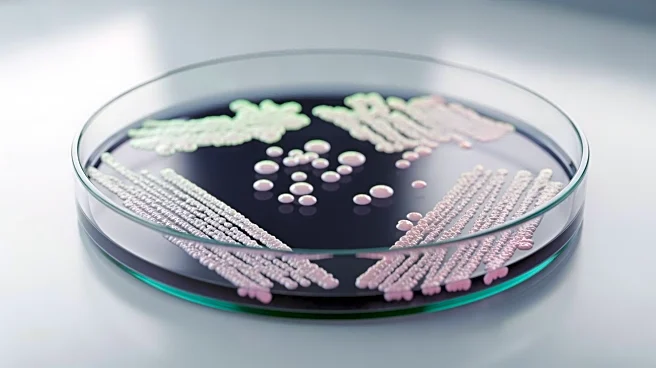
Gut Bacteria Turicibacter Found to Reduce Weight Gain in Mice

What's Happening?
Researchers from Imperial College London have identified a small molecule, trimethylamine (TMA), produced by gut bacteria, which may play a crucial role in managing and preventing type 2 diabetes. TMA is a bacterial metabolite that has been shown to reduce
inflammation and improve insulin response, thereby lowering the risk of type 2 diabetes. The study, conducted on human cell models and lab mice, suggests that TMA can mitigate some of the damage caused by high-fat diets. The molecule is produced when gut microbes break down choline, a nutrient found in foods like eggs and meat. By increasing choline in high-fat diets, researchers observed a reduction in the negative effects of such diets. TMA's ability to inhibit the IRAK4 protein, which triggers inflammation, is a key mechanism in this protective effect.
Why It's Important?
The findings of this study are significant as they offer a potential new approach to managing insulin resistance and type 2 diabetes, conditions that are prevalent and pose serious health risks globally. The ability of TMA to reduce inflammation and improve insulin response could lead to new therapeutic strategies that utilize the microbiome to combat diabetes and its complications, such as heart disease. This research highlights the importance of gut health and its impact on overall health, suggesting that dietary interventions or microbiome-based therapies could be developed to prevent or treat diabetes. The study also opens up new avenues for targeting kinases, like IRAK4, through microbiome-based interventions, potentially revolutionizing the treatment of obesity and diabetes.
What's Next?
Future research will need to replicate these findings in human participants over extended periods to confirm the efficacy and safety of TMA as a therapeutic agent. If successful, this could lead to the development of new drugs or dietary recommendations that leverage the gut microbiome to manage or prevent type 2 diabetes. The study's implications for targeting kinases with microbiome-based therapies could also spur further research into other diseases linked to inflammation and metabolic disorders. As the understanding of the gut-brain axis and microbiome's role in health expands, more innovative treatments may emerge, potentially transforming the landscape of metabolic disease management.